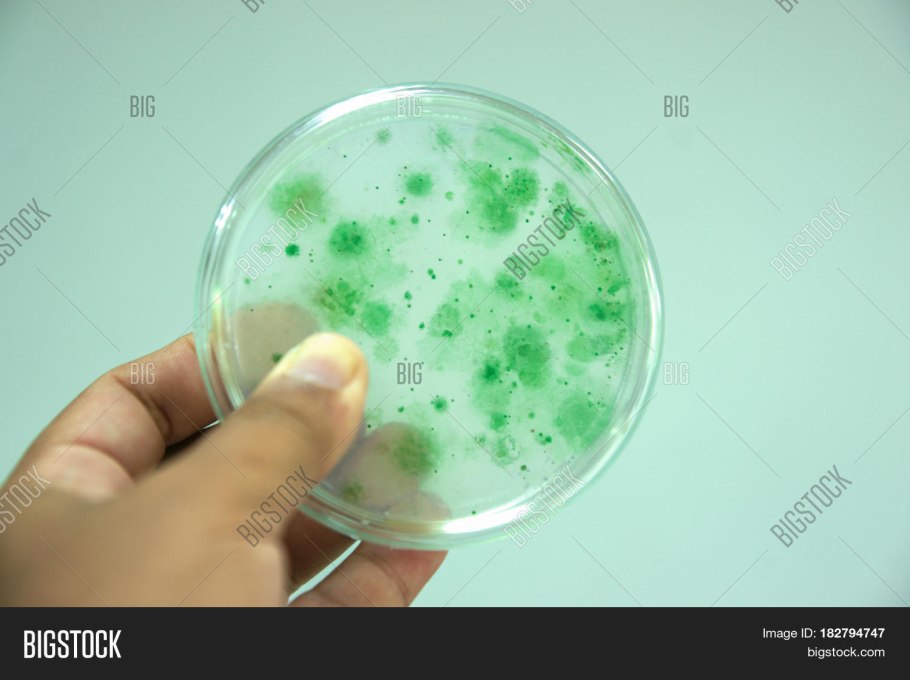

Зеленые водоросли плавающие густой массой

Нейстон водоросли

Речные водоросли на белом

Зеленые водоросли Тина

Водоросль хлороглея сарциноидная

FRZ.Temp холодильник

Водоросли в луже

Морские водоросль куст

Spirulina SP. – Спирулина

Цветение воды цианобактерии

Биологическое загрязнение воды

Спирогира водоросль

Рост водорослей в Волге

Myriophyllum verticillatum

Сине-зеленые водоросли в природе

Riccia Fluitans/ риччия Флуитанс

Цветение воды цианобактерии

Цветение воды цианобактерии

Водоросль морская капуста ламинария

Желтое море зеленые водоросли

Цветение микроводорослей

Цветение воды цианобактерии

Риччия акваскейп

Ульва Эстетика

Аэрофильные водоросли

Микроводоросль хлорелла

Цветение воды цианобактерии

Тина мох

Цианобактерии в чашке Петри

Рыбы живущие в водорослях

Спирогира это автотроф
Зостера морская водоросль

Уруть озеро Байкал

Желто зеленые водоросли

Бурые водоросли в Арктике

Хромофиты водоросли

Бурые водоросли вакамэ

Лессония ламинариевидная

Зеленые водоросли Chlorophyta

Ламинария макроцистис

Subnautica лес водорослей

Кувшинки под водой

Водоросли ламинария

Galaxaura filamentosa водоросли

Мох риччия

Зеленая вода в море

Цианобактерии в воде

Водоросли загрязнение озер камыш

Ооцистис водоросль

Микроскопические водоросли

Текстура слизи

Ламинария Пресноводная

Лимнобиум побегоносный - (Limnobium stoloniferum)

Девушка в водорослях

Эгагропила Линнея

Канал с водой зеленой

Водоросли биоиндикаторы

Желтое море зеленые водоросли

Мох риччия

Риччия Амано

Синезеленые водоросли

Желтое море китай

Риччия флуитанс

Мох риччия

Цветение воды цианобактерии
Поделиться фото в социальных сетях:
Комментариев (0)
Похожие фото:











